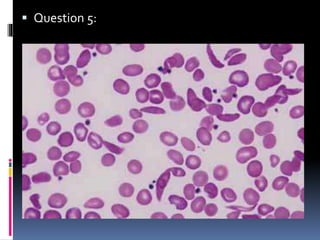
 Question 5:
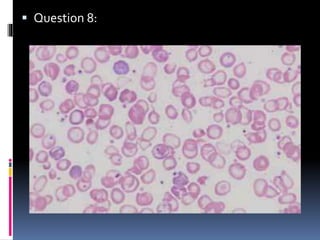
 Question 8:
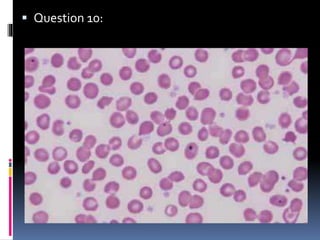
 Question 10:
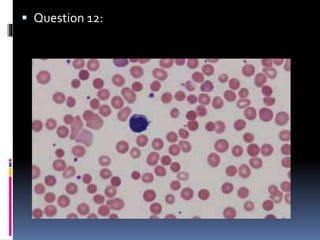
 Question 12:
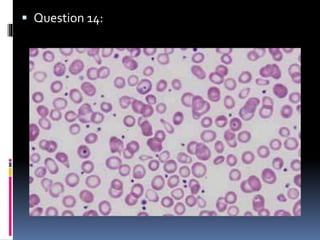
 Question 14:
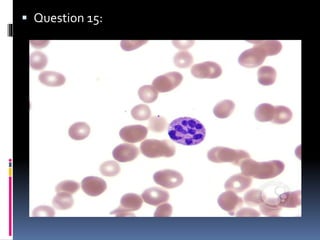
 Question 15:
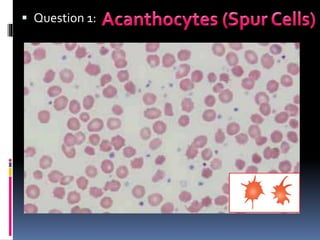
 Question 1:
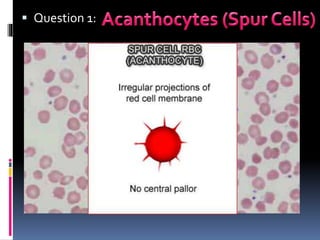
 Question 1:
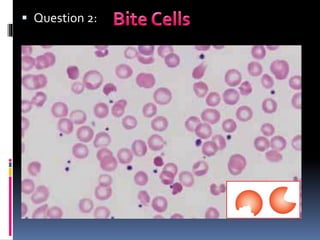
 Question 2:
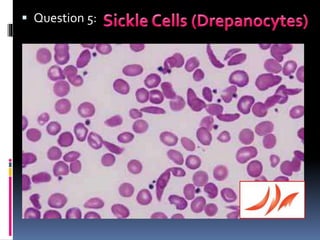
 Question 5:
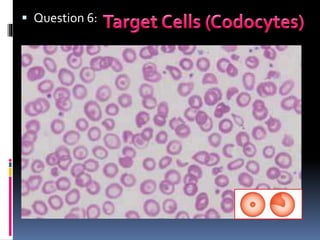
 Question 6:
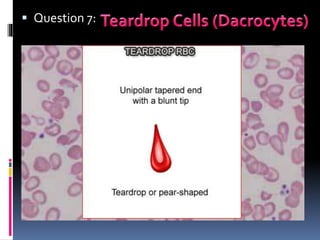
 Question 7:
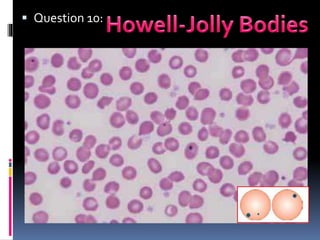
 Question 10:
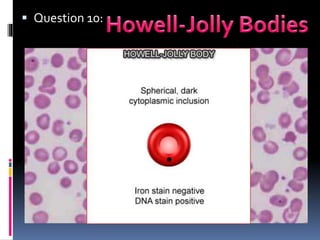
 Question 10:
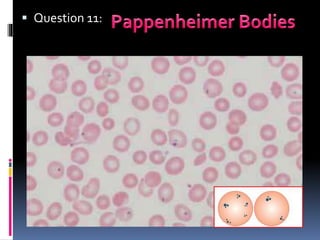
 Question 11:
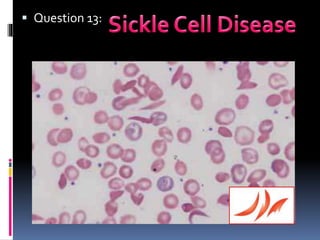
 Question 13:
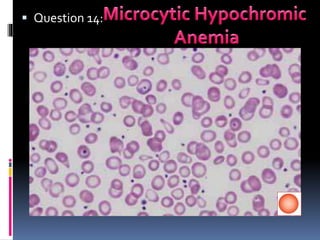
 Question 14:
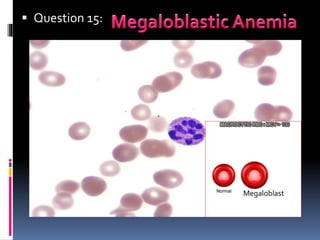
 Question 15:
Megaloblast
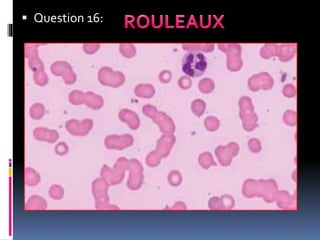
 Question 16:

This document contains 16 questions about abnormal red blood cell morphologies seen on blood smears. Each question describes a different abnormal red blood cell type (acanthocytes, bite cells, etc.) and lists the conditions commonly associated with each type, such as hereditary diseases, infections, nutritional deficiencies. Common findings include acanthocytes in abetalipoproteinemia; bite cells in G6PD deficiency; sickle cells in sickle cell anemia; Howell-Jolly bodies and Pappenheimer bodies in spleen disorders; and rouleaux in infections. References include pediatric textbooks and online hematology resources.